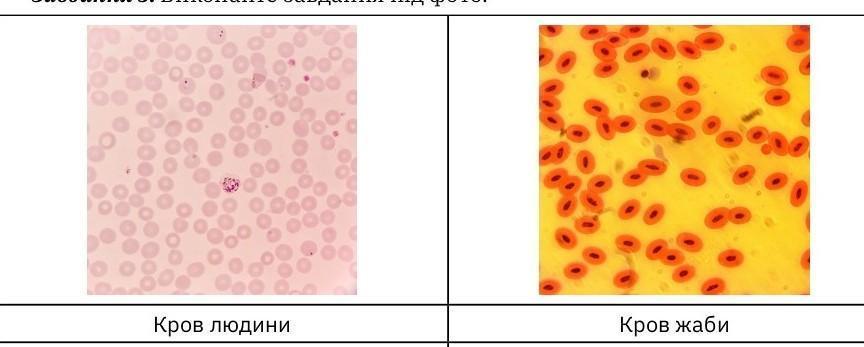

потрібна допомога будь ласка!!!
1) Кров людини
Питання: Які формені елементи крові ви бачите?
Відповідь:
Питання: Яка структура відсутня в цих клітин?
Відповідь:
2) Кров жаби
Питання: Які формені елементи крові ви бачите?
Відповідь:
Питання: Що відмінного у будові цих клітин у порівнянні з кров’ю людини?
Відповідь:
Приложения:
Ответы
Ответ дал:
13
Объяснение:
У крові людини можна знайти три найголовніших формених тільця: еритроцити, лейкоцити та тромбоцити. Еритроцити мають двояковогнуту структуру для транспортування кисню та вуглекислого газу. Не мають ядра. Лейкоцити мають ядро, слугують захисниками нашого організму від паразитів та патогенних мікроорганізмів. Тромбоцити беруть участь у звертанні крові.
На другому малюнку у крові жаби можна побачити дуже багато еритроцитів. Це можна пояснити тим, що жаба мешкає в місцях постійного кисневого обміну, саме через це, їй необхідна наявність багатьох клітин еритроцитів. На відмінну від еритроцитів людини, еритроцити жаби більш пухкі та великі.
Вас заинтересует
1 год назад
1 год назад
1 год назад
1 год назад
8 лет назад